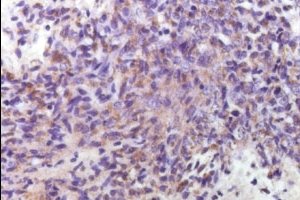
Лимфогранулематоз: причины, симптомы и лечение

Лимфогранулематоз — онкологическое заболевание лимфоидной ткани, у которого имеется специфическая гистологическая структура. Данное заболевание было впервые описано в 1832 английским врачом Томасом Ходжкиным, в честь которого и получила свое второе название — болезнь Ходжкина. Врач наблюдал семь пациентов с увеличенными лимфатическими узлами. Лимфогранулематоз чаще всего диагностируется у европеоидной расы. Заболевание может появиться у человека в любом возрасте, однако пик заболеваний приходится на две возрастные категории: первая — от 20 до 29 лет, вторая — у лиц старше 50 лет. Лимфогранулематоз встречается с одинаковой частотой как у мужчин, так и у женщин.
Причины возникновения заболевания
Причина, по которой у больного появляется лимфогранулематоз, остается невыясненной по сей день. Однако по некоторым предположениям, болезнь бывает вызвана вирусом Эпштейна-Барра. Ген этого вируса обнаруживается при исследовании биопсийного материала в 20-60% случаев у больных лимфогранулематозом. Вирус Эпштейна-Барра вызывает в лимфоцитах многочисленные мутации, после чего здоровые клетки перерождаются в опухолевые. К другим предположениям относят наследственный фактор и воздействие некоторых химических веществ.
Врачи отмечают, что лимфогранулематоз, или болезнь Ходжкина, является злокачественным заболеванием лимфатической системы. Основные причины его возникновения до конца не изучены, однако генетическая предрасположенность и воздействие вирусов, таких как Epstein-Barr, могут играть значительную роль. Симптомы заболевания часто включают увеличенные лимфатические узлы, лихорадку, ночные поты и потерю веса. Врачи подчеркивают важность ранней диагностики, так как это значительно увеличивает шансы на успешное лечение. Современные методы терапии включают химиотерапию, радиотерапию и в некоторых случаях трансплантацию стволовых клеток. Специалисты рекомендуют регулярные медицинские осмотры для выявления заболевания на ранних стадиях, что позволяет значительно улучшить прогноз для пациентов.

Симптомы лимфогранулематоза
Главное проявление заболевания — это увеличение шейных, подмышечных и паховых лимфатических узлов. Заболевание, как правило, характеризуется безболезненностью, плотностью и подвижностью лимфоузлов. Кроме того, в отличие от инфекционных заболеваний, лимфоузлы при лимфогранулематозе не приходят в норму после приема антибиотиков. Данное заболевание часто сопровождается поражением ткани в грудной клетке, что в итоге вызывает сильный кашель или затрудняет дыхание.
Также лимфогранулематоз сопровождается и другими симптомами:
-
повышением температуры тела;
-
потливостью;
-
слабостью;
-
повышенной утомляемостью;
-
пищеварительными расстройствами;
-
стремительной потерей веса.
Диагностика лимфогранулематоза
Если врач после очного осмотра заподозрил болезнь Ходжкина, он назначает пациенту анализ крови (общий и биохимический), а также биопсию лимфоузла, с проведением морфологического и иммунологического исследования.
Главный метод диагностики при лимфогранулематозе, который может подтвердить или опровергнуть диагноз — это микроскопическое исследование взятого образца ткани лимфоузла. Заболевание диагностируется, если в ткани наблюдаются гигантские клетки Березовского-Штернберга-Рида.
Чтобы определить параметры раковых клеток, целесообразно провести иммуногистохимические исследования. Определить стадию лимфогранулематоза позволяют методы лучевой диагностики: рентгенография, магнитно-резонансная томография и компьютерная томография.
Лимфогранулематоз, или болезнь Ходжкина, вызывает множество обсуждений среди пациентов и врачей. Люди часто делятся своими переживаниями о том, как болезнь влияет на их жизнь. Основные причины возникновения остаются не до конца изученными, но считается, что генетическая предрасположенность и вирусные инфекции могут играть роль. Симптомы, такие как увеличение лимфатических узлов, лихорадка, потливость и потеря веса, часто пугают пациентов, заставляя их обращаться за помощью. Лечение включает химиотерапию и радиотерапию, и многие отмечают, что современные методы значительно увеличивают шансы на выздоровление. Важно, чтобы пациенты не теряли надежду и искали поддержку у близких и специалистов.

Лечение лимфогранулематоза
Начальные стадии заболевания, то есть первая и вторая, лечатся, как правило, при помощи лучевой терапии, которая позволяет добиться длительной ремиссии заболевания в 85% случаев. Этот метод лечения осуществляется при помощи специальных аппаратов, длительное время облучающих лимфатические узлы. Специальные свинцовые фильтры помогают защитить от облучения здоровые ткани.
Второй способ лечения болезни Ходжкина — химиотерапия, один из циклов которой составляет 28 дней. Курс лечения длится пол года.
Также очень часто наблюдается сочетание этих двух методов лечения, которое в 90% случаев позволяет добиться ремиссии лимфогранулематоза на 10-12 лет.
Вопрос-ответ

Как начинаются лимфогранулематоз симптомы?
Незначительное, но стойкое увеличение температуры тела, усиление потоотделения по ночам, потерю аппетита, снижение веса, общую утомляемость и слабость.
Какой из симптомов является наиболее частым, ранним и характерным признаком лимфогранулематоза?
Основным и самым первым признаком лимфогранулематоза является увеличение одного или нескольких лимфатических узлов. Как правило, страдают шейные или надключичные группы, реже паховые, бедренные и подмышечные.
Кто чаще болеет лимфогранулематозом?
Заболеваемость лимфогранулематозом составляет ок. 2. 5 случаев на 100 000 населения/год. Чаще болеют мужчины. Относительное увеличение заболеваемости лимфогранулематозом наблюдается у пациентов в возрасте 15-35 лет, а также улиц старше 50 лет, описаны отдельные случаи лимфогранулематоза и у новорожденных.
Каковы первые признаки и симптомы лимфомы Ходжкина?
Лимфома Ходжкина – это опухолевые образования лимфоидной ткани, которые по морфологическим и симптоматическим критериям разделяются на несколько типов. Каждый из них развивается по собственному патологическому сценарию и требует специального протокола лечения. Классификация заболевания: Классический лимфогранулематоз.
Советы
СОВЕТ №1
Обратите внимание на ранние симптомы. Лимфогранулематоз может проявляться в виде увеличенных лимфатических узлов, ночной потливости, усталости и необъяснимой потери веса. Если вы заметили такие симптомы, не откладывайте визит к врачу.
СОВЕТ №2
Регулярно проходите медицинские обследования. Особенно это касается людей, находящихся в группе риска. Ранняя диагностика может значительно повысить шансы на успешное лечение.
СОВЕТ №3
Изучите варианты лечения. Лимфогранулематоз может лечиться различными методами, включая химиотерапию и радиотерапию. Обсудите с врачом все доступные варианты и выберите тот, который подходит именно вам.
СОВЕТ №4
Поддерживайте здоровый образ жизни. Правильное питание, регулярные физические нагрузки и отказ от вредных привычек помогут укрепить иммунную систему и улучшить общее состояние организма во время лечения.